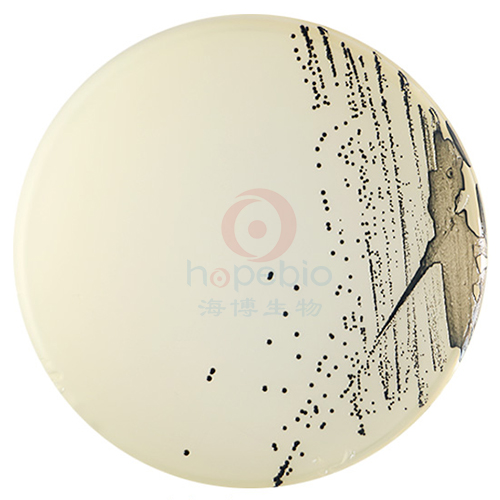

用途:用于金黄色葡萄球菌的选择性分离培养。
添加剂:每瓶需配套添加 5盒 HB4116-1 亚碲酸盐卵黄增菌液 使用,每95mlBaird-Parker琼脂基础中添加1支。
成分(g/L)
胰蛋白胨
|
10.0
|
牛肉浸粉
|
5.0
|
酵母浸粉
|
1.0
|
丙酮酸钠
|
10.0
|
甘氨酸
|
12.0
|
氯化锂
|
5.0
|
琼脂
|
20.0
|
pH值 7.0 ± 0.2
|
25℃
|
检验原理:
胰蛋白胨、牛肉浸粉和酵母浸粉提供碳氮源、维生素和生长因子;丙酮酸钠和甘氨酸刺激葡萄球菌的生长;氯化锂和亚碲酸钾抑制非葡萄球菌的微生物;含有卵磷脂酶的葡萄球菌降解卵黄使菌落产生透明圈,而脂酶作用则产生不透明的沉淀环;凝固酶阳性的葡萄球菌还能还原亚碲酸钾而产生黑色菌落;琼脂是培养基的凝固剂。
用法:
称取本品 63.0g,加热搅拌溶解于 950ml 蒸馏水中,分装每瓶 95ml,121℃高压灭菌 15 分钟,临用前加热溶化琼脂,冷至 50℃左右,于每 95ml 培养基中加入常温解冻的卵黄亚碲酸钾增菌剂 5ml 摇匀后倾入无菌平皿。
质量控制和典型特征
在 36±1℃培养 45-48h,金黄色葡萄球菌的单个菌落呈圆形,表面光滑、凸起、湿润,直径 2-3mm。灰黑色至黑色,有光泽,常有浅色(非白色)的边缘,周围绕以不透明圈(沉淀),其外常有一清晰带。
Baird-Parker琼脂基础培养基原理及使用方法:/asphtml/refere9452.htm
Baird-Parker琼脂上细菌菌落特征:
|

|

|
|
Baird-Parker琼脂
金黄色葡萄球菌ATCC25923
|
Baird-Parker琼脂
金黄色葡萄球菌ATCC25923(单个菌落)
|
|
|
|
Baird-Parker琼脂
表皮葡萄球菌CMCC26069
|
Baird-Parker琼脂(颗粒)微生物灵敏度试验:
按标签用法制备培养基,接种以下质控菌株,放置36±1℃需氧培养45-48小时。

科普:金黄色葡萄球菌:/asphtml/video63.htm


 海博微信公众号
海博微信公众号
 海博天猫旗舰店
海博天猫旗舰店


 海博微信公众号
海博微信公众号
 海博天猫旗舰店
海博天猫旗舰店






